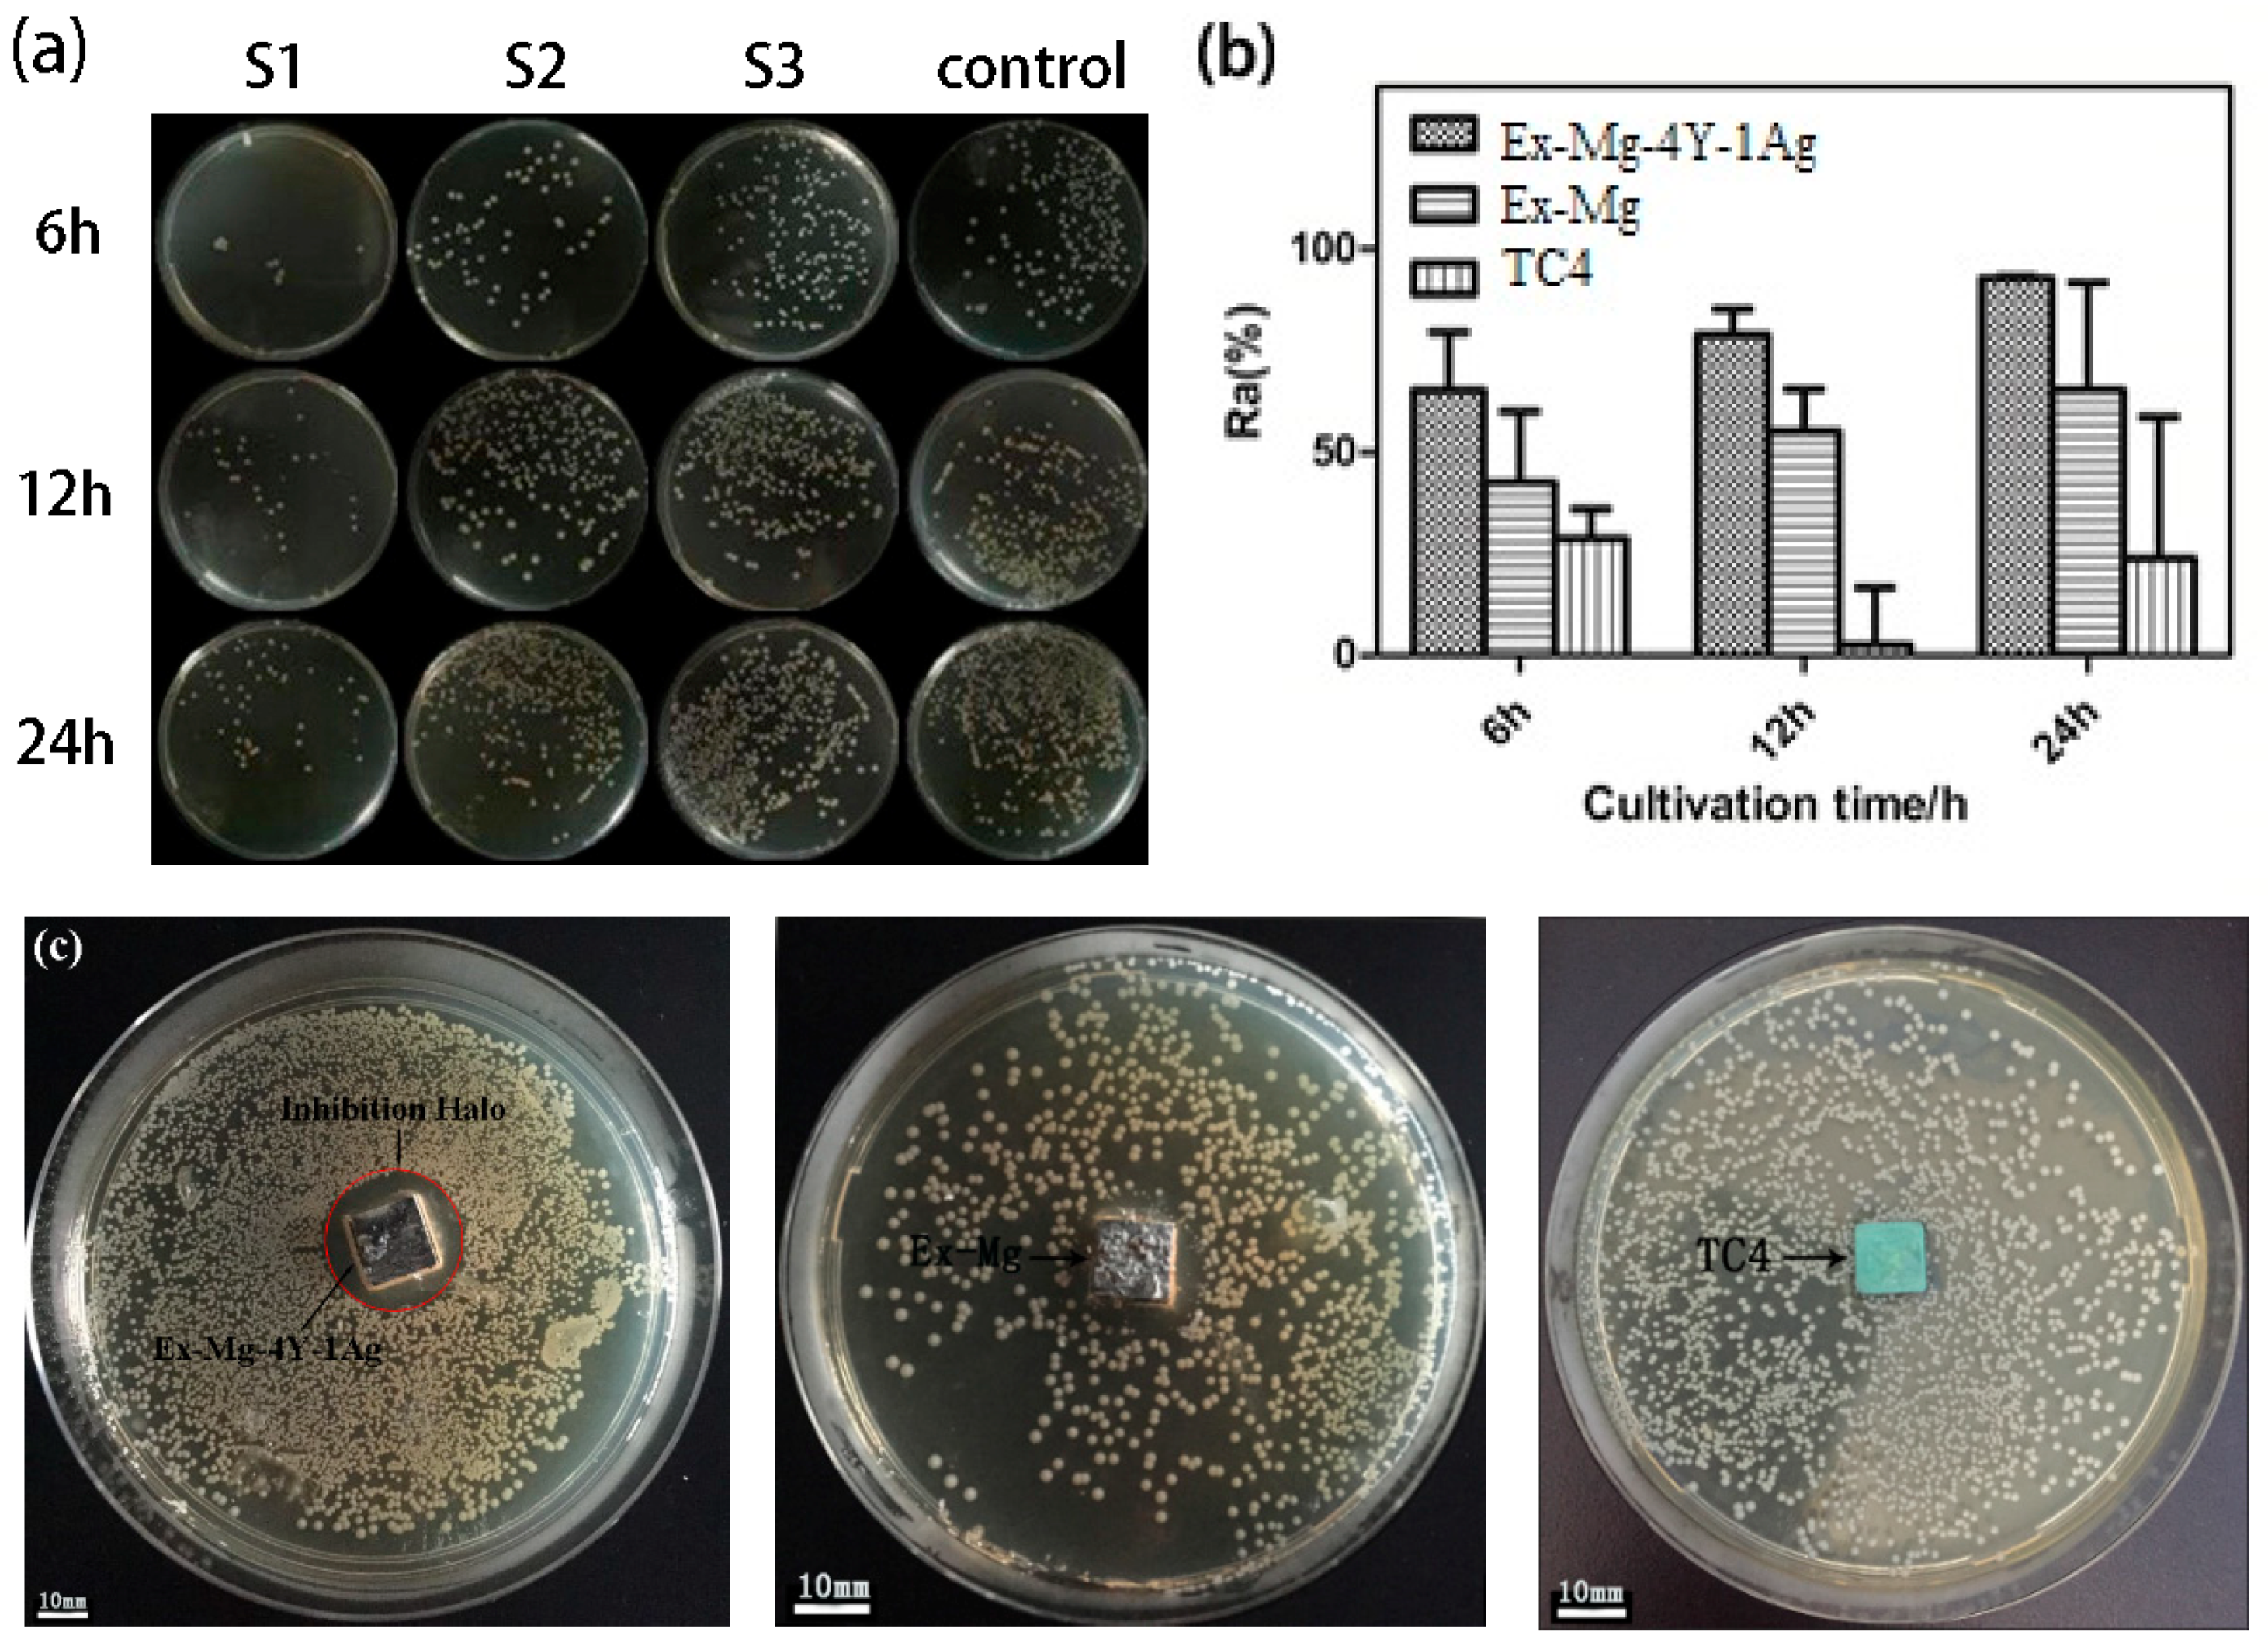
Metals 08 00948 g006 Metals 08 00948 g006

A Potential Biodegradable Mg-Y-Ag Implant with Strengthened Antimicrobial Properties in Orthopedic Applications
Abstract
1. Introduction
2. Materials and Methods
2.1. Sample Preparation
2.2. Mechanical and Metallurgical Testing
2.3. In Vitro Corrosion Testing
2.4. Antibacterial and Ion Concentration Testing
2.5. Cell Toxicity Experiment
2.6. Statistical Analysis
3. Results
3.1. Microstructure of Mg-4Y-1Ag Alloys
3.2. Mechanical Property of Mg-4Y-1Ag Alloys
3.3. In Vitro Corrosion Test
3.4. Antibacterial Test
3.5. Cytotoxicity Test
4. Discussion
5. Conclusions
- (1)
- Hot-extrusion make Mg-4Y-1Ag alloys get smaller grain size and eliminate the second dendrites, which can greatly promote the corrosion resistance of Mg-4Y-1Ag. The degradation rate of Ex-Mg-4Y-1Ag is close to Ex-Mg. The incorporation of oxidized Y in the surface film is identified as enhancing the degradation resistance of Mg-4Y-1Ag alloys.
- (2)
- The Ex-Mg-4Y-1Ag alloys show acceptable strengths, elastic moduli and elongation. The densities and elastic moduli of the alloys match those of natural bone, and the strengths and elongation are larger than that of natural bone.
- (3)
- Compared to Ex-Mg and TC4, the Ex-Mg-4Y-1Ag alloy possesses significant antibacterial effect toward S. aureus for its released Ag+ ion and shows no cytotoxicity to L929 cells.
Author Contributions
Funding
Conflicts of Interest
References
- Witte, F. Reprint of the history of biodegradable magnesium implants: A review. Acta Biomater. 2015, 23, S28–S40. [Google Scholar] [CrossRef] [PubMed]
- Zhang, Y.; Xu, J.; Ruan, Y.C.; Yu, M.K.; O’Laughlin, M.; Wise, H.; Chen, D.; Tian, L.; Shi, D.; Wang, J.; et al. Implant-derived magnesium induces local neuronal production of CGRP to improve bone-fracture healing in rats. Nat. Med. 2016, 22, 1160–1169. [Google Scholar] [CrossRef] [PubMed]
- Yu, K.; Chen, L.; Zhao, J.; Li, S.; Dai, Y.; Huang, Q.; Yu, Z. In vitro corrosion behavior and in vivo biodegradation of biomedical β-Ca3(PO4)2/Mg-Zn composites. Acta Biomater. 2012, 8, 2845–2855. [Google Scholar] [CrossRef] [PubMed]
- Song, G.L.; Song, S.Z. A possible biodegradable magnesium implant material. Adv. Eng. Mater. 2007, 9, 298–302. [Google Scholar] [CrossRef]
- Mueller, W.D.; Nascimento, M.L.; de Mele, M. Critical discussion of the results from different corrosion studies of Mg and Mg alloys for biomaterial applications. Acta Biomater. 2010, 6, 1749–1755. [Google Scholar] [CrossRef] [PubMed]
- Kirkland, N.T.; Birbilis, N.; Staiger, M.P. Assessing the corrosion of biodegradable magnesium implants: A critical review of current methodologies and their limitations. Acta Biomater. 2012, 8, 925–936. [Google Scholar] [CrossRef] [PubMed]
- Witte, F.; Hort, N.; Vogt, C.; Cohen, S.; Kainer, K.U.; Willumeit, R.; Feyerabend, F. Degradable biomaterials based on magnesium corrosion. Curr. Opin. Solid State Mater. Sci. 2008, 12, 63–72. [Google Scholar] [CrossRef]
- Shi, Z.; Song, G.; Atrens, A. Corrosion resistance of anodised single-phase Mg alloys. Surf. Coat. Technol. 2006, 201, 492–503. [Google Scholar] [CrossRef]
- Hedayati, R.; Ahmadi, S.M.; Lietaert, K.; Tã Mer, N.; Li, Y.; Amin, Y.S.; Zadpoor, A.A. Fatigue and quasi-static mechanical behavior of bio-degradable porous biomaterials based on magnesium alloys. J. Biomed. Mater. Res. A 2018, 106, 1798–1811. [Google Scholar] [CrossRef] [PubMed]
- Peron, M.; Torgersen, J.; Berto, F. Mg and its alloys for biomedical applications: Exploring corrosion and its interplay with mechanical failure. Metals 2017, 7, 252. [Google Scholar] [CrossRef]
- Du, H.; Wei, Z.; Liu, X.; Zhang, E. Effects of Zn on the microstructure, mechanical property and bio-corrosion property of Mg-3Ca alloys for biomedical application. Mater. Chem. Phys. 2011, 125, 568–575. [Google Scholar] [CrossRef]
- Tie, D.; Feyerabend, F.; Hort, N.; Hoeche, D.; Kainer, K.U.; Willumeit, R.; Mueller, W.D. In vitro mechanical and corrosion properties of biodegradable Mg-Ag alloys. Mater. Corros. 2014, 65, 569–576. [Google Scholar] [CrossRef]
- Tie, D.; Feyerabend, F.; Müller, W.; Schade, R.; Liefeith, K.; Kainer, K.U.; Willumeit, R. Antibacterial biodegradable Mg-Ag alloys. Eur. Cell. Mater. 2013, 25, 284–298. [Google Scholar] [CrossRef] [PubMed]
- Feyerabend, F.; Fischer, J.; Holtz, J.; Witte, F.; Willumeit, R.; Drucker, H.; Vogt, C.; Hort, N. Evaluation of short-term effects of rare earth and other elements used in magnesium alloys on primary cells and cell lines. Acta Biomater. 2010, 6, 1834–1842. [Google Scholar] [CrossRef] [PubMed]
- He, W.; Zhang, E.; Yang, K. Effect of Y on the bio-corrosion behavior of extruded Mg–Zn–Mn alloy in Hank’s solution. Mater. Sci. Eng. C 2010, 30, 167–174. [Google Scholar] [CrossRef]
- Nayak, S.; Bhushan, B.; Jayaganthan, R.; Gopinath, P.; Agarwal, R.D.; Lahiri, D. Strengthening of Mg based alloy through grain refinement for orthopaedic application. J. Mech. Behav. Biomed. 2016, 59, 57. [Google Scholar] [CrossRef] [PubMed]
- Yan, Y.; Kang, Y.; Li, D.; Yu, K.; Xiao, T.; Deng, Y.; Dai, H.; Dai, Y.; Xiong, H.; Fang, H. Improvement of the mechanical properties and corrosion resistance of biodegradable β-Ca3(PO4)2/Mg-Zn composites prepared by powder metallurgy: The adding β-Ca3(PO4)2, hot extrusion and aging treatment. Mater. Sci. Eng. C Mater. Biol. Appl. 2017, 74, 582. [Google Scholar] [CrossRef] [PubMed]
- Vlček, M.; Lukáč, F.; Kudrnová, H.; Smola, B.; Stulíková, I.; Luczak, M.; Szakács, G.; Hort, N.; Willumeit-Römer, R. Microhardness and In Vitro Corrosion of Heat-Treated Mg-Y-Ag Biodegradable Alloy. Materials 2017, 10, 55. [Google Scholar] [CrossRef] [PubMed]
- Song, G.; Atrens, A.; Stjohn, D. An Hydrogen Evolution Method for the Estimation of the Corrosion Rate of Magnesium Alloys; John Wiley & Sons, Inc.: Hoboken, NJ, USA, 2013; pp. 255–262. [Google Scholar]
- Peng, Q.; Huang, Y.; Zhou, L.; Hort, N.; Kainer, K.U. Preparation and properties of high purity Mg-Y biomaterials. Biomaterials 2010, 31, 398–403. [Google Scholar] [CrossRef] [PubMed]
- Chen, Y.; Xu, Z.; Smith, C.; Sankar, J. Recent advances on the development of magnesium alloys for biodegradable implants. Acta Biomater. 2014, 10, 4561–4573. [Google Scholar] [CrossRef] [PubMed]
- Pereda, M.D.; Alonso, C.; Burgos-Asperilla, L.; Del Valle, J.A.; Ruano, O.A.; Perez, P.; Ma, F.N.L.D. Corrosion inhibition of powder metallurgy Mg by fluoride treatments. Acta Biomater. 2010, 6, 1772–1782. [Google Scholar] [CrossRef] [PubMed]
- Liu, M.; Schmutz, P.; Uggowitzer, P.J.; Song, G.; Atrens, A. The influence of yttrium (Y) on the corrosion of Mg–Y binary alloys. Corros. Sci. 2010, 52, 3687–3701. [Google Scholar] [CrossRef]
- Zhou, W.; Shan, D.; Han, E.H.; Ke, W. Structure and formation mechanism of phosphate conversion coating on die-cast AZ91D magnesium alloy. Corros. Sci. 2008, 50, 329–337. [Google Scholar] [CrossRef]
- Lebouil, S.; Duboin, A.; Monti, F.; Tabeling, P.; Volovitch, P.; Ogle, K. A novel approach to on line measurement of gas evolution kinetics: Application to the negative difference effect of Mg in chloride solution. Electrochim. Acta 2014, 124, 176–182. [Google Scholar] [CrossRef]
- Witte, F.; Fischer, J.; Nellesen, J.; Crostack, H.A.; Kaese, V.; Pisch, A.; Beckmann, F.; Windhagen, H. In vitro and in vivo corrosion measurements of magnesium alloys. Biomaterials 2006, 27, 1013–1018. [Google Scholar] [CrossRef] [PubMed]
- Abidin, N.I.Z.; Martin, D.; Atrens, A. Corrosion of high purity Mg, AZ91, ZE41 and Mg2Zn0.2Mn in Hank’s solution at room temperature. Corros. Sci. 2011, 53, 862–872. [Google Scholar] [CrossRef]
- Peng, Q.; Fu, H.; Pang, J.; Zhang, J.; Xiao, W. Preparation, mechanical and degradation properties of Mg-Y-based microwire. J. Mech. Behav. Biomed. 2014, 29, 375–384. [Google Scholar] [CrossRef] [PubMed]
- Ye, X.; Chen, M.; Yang, M.; Wei, J.; Liu, D. In vitro corrosion resistance and cytocompatibility of nano-hydroxyapatite reinforced Mg-Zn-Zr composites. J. Mater. Sci. Mater. Med. 2010, 21, 1321. [Google Scholar] [CrossRef] [PubMed]
- Zhang, Y.; Yan, C.; Wang, F.; Li, W. Electrochemical behavior of anodized Mg alloy AZ91D in chloride containing aqueous solution. Corros. Sci. 2005, 47, 2816–2831. [Google Scholar] [CrossRef]
- Fu, H.M.; Qiu, D.; Zhang, M.X.; Wang, H.; Kelly, P.M.; Taylor, J.A. The development of a new grain refiner for magnesium alloys using the edge-to-edge model. J. Alloys Compd. 2008, 456, 390–394. [Google Scholar] [CrossRef]

| Samples | Elastic Modulus/GPa | Yield Stress/MPa | Ultimate Tensile Stress/MPa | Elongation/% |
|---|---|---|---|---|
| C-Mg-4Y-1Ag | 40 | 67 | 146 | 3.8 |
| Ex-Mg-4Y-1Ag | 37 | 102 | 211 | 40.4 |
| Ex-Mg | 21 | 83 | 163 | 9.3 |
| TC4 | 112 | 891 | 986 | 13.0 |
| Natural Bone | 3–20 | - | 130–180 | 1.07–2.10 |
| Samples | Ecorr/V | Icorr/μA | Rp/KΩ |
|---|---|---|---|
| C-Mg-4Y-1Ag | −1.537 | 13.2 | 0.732 |
| Ex-Mg-4Y-1Ag | −1.464 | 5.38 | 1.521 |
| Ex-Mg | −1.791 | 4.92 | 1.922 |
| Samples | Rs | Y1 | n1 | Rt | Y2 | n2 | Rf |
|---|---|---|---|---|---|---|---|
| (Ω·cm2) | (μΩ−1·cm−2·s−1) | (Ω·cm2) | (μΩ−1·cm−2·s−1) | (Ω·cm2) | |||
| Ex-Mg | 1.830 | 13.47 | 0.9499 | 665.0 | 0.9342 | 1 | 2.404 |
| Ex-Mg-4Y-1Ag | 1.803 | 26.32 | 0.9524 | 430.9 | 45.42 | 0.6483 | 521.6 |
| CR (mm/year) Materials | 72 h | 120 h | 300 h | 1 month |
|---|---|---|---|---|
| Mg | 1.22 | 1.16 | 0.95 | 0.42 |
| Ex-Mg-4Y-1Ag | 2.36 | 1.52 | 0.86 | 0.35 |
© 2018 by the authors. Licensee MDPI, Basel, Switzerland. This article is an open access article distributed under the terms and conditions of the Creative Commons Attribution (CC BY) license (http://creativecommons.org/licenses/by/4.0/).
Share and Cite
Dai, Y.; Liu, H.; Tang, Y.; Xu, X.; Long, H.; Yan, Y.; Luo, Z.; Zhang, Y.; Yu, K.; Zhu, Y. A Potential Biodegradable Mg-Y-Ag Implant with Strengthened Antimicrobial Properties in Orthopedic Applications. Metals 2018, 8, 948. https://doi.org/10.3390/met8110948
Dai Y, Liu H, Tang Y, Xu X, Long H, Yan Y, Luo Z, Zhang Y, Yu K, Zhu Y. A Potential Biodegradable Mg-Y-Ag Implant with Strengthened Antimicrobial Properties in Orthopedic Applications. Metals. 2018; 8(11):948. https://doi.org/10.3390/met8110948
Chicago/Turabian StyleDai, Yilong, Hui Liu, Yifu Tang, Xuemei Xu, Haitao Long, Yang Yan, Zhenhua Luo, Yu Zhang, Kun Yu, and Yong Zhu. 2018. "A Potential Biodegradable Mg-Y-Ag Implant with Strengthened Antimicrobial Properties in Orthopedic Applications" Metals 8, no. 11: 948. https://doi.org/10.3390/met8110948
APA StyleDai, Y., Liu, H., Tang, Y., Xu, X., Long, H., Yan, Y., Luo, Z., Zhang, Y., Yu, K., & Zhu, Y. (2018). A Potential Biodegradable Mg-Y-Ag Implant with Strengthened Antimicrobial Properties in Orthopedic Applications. Metals, 8(11), 948. https://doi.org/10.3390/met8110948

